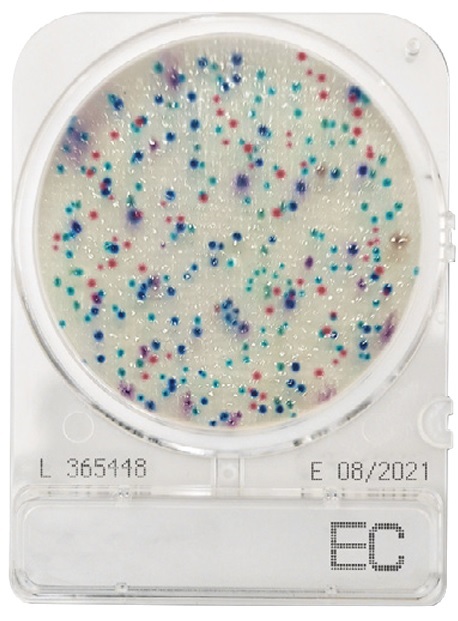

CompactDry TC (Contagem Total), cx. 240 placas
Preço sob consulta
Filtro de seringa Nylon não estéril, 13 mm, 0.2 µm, cx. 100 unid’s
Preço sob consulta
CompactDry EC (Escherichia coli e coliformes), cx. 240 placas
267,86€ sem IVA
Marca: CompactDry
Disponível por encomenda
REF:
1000169
Categorias: Em placa, Meios de Cultura
Descrição
CompactDry EC é uma placa de meio desidratada, usada para detetar E. coli e bactérias coliformes em alimentos e bebidas..;
A presença de bactérias coliformes é um indicador de contaminação fecal e possível presença de patógenos na água, peixe e marisco, laticínios e outros alimentos.;
A monitorização e identificação de E. coli e coliformes são utilizados em cada etapa do processo de produção de alimentos como parâmetro de controle de qualidade.;